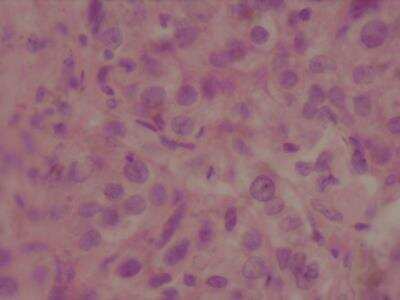

Human Breast Tissue Lysate (Adult Tumor)
Novus Biologicals, part of Bio-Techne | Catalog # NBP2-28004

Key Product Details
Species
Human
Product Summary for Human Breast Tissue Lysate (Adult Tumor)
The vial is provided with a 10% overfill. Maximum recovery can be obtained by centrifuging the vial briefly to collect any solution on the cap and tube sides.
Product Specifications
Application Notes
These lysates are proteomic discovery tools.Researchers should validate and optimize for individual use. Potential applications MAY include WB, immunoprecipitation, protein-protein interactions, ligand binding, ELISA.
Note: For use in 1D and 2D gel electrophoresis, the addition of a denaturing gel loading buffer with reducing agents may be required.
Note: For use in 1D and 2D gel electrophoresis, the addition of a denaturing gel loading buffer with reducing agents may be required.
Specificity
Sex:female
Age :55
Diagnosis:Solid adenocarcinoma
Grade:3
Stage:II
TNM:T2N1M0
Clinical Tissue
Human Breast Tumor Tissue Lysate, Soluble protein fraction
Age :55
Diagnosis:Solid adenocarcinoma
Grade:3
Stage:II
TNM:T2N1M0
Clinical Tissue
Human Breast Tumor Tissue Lysate, Soluble protein fraction
Type
Tissue
Life Stage
Adult
Tissue
Breast
Tissue Condition
Tumor
Scientific Data Images for Human Breast Tissue Lysate (Adult Tumor)
Human Breast Tissue Lysate (Adult Tumor) [NBP2-28004]
Human Breast Tissue Lysate (Adult Tumor) [NBP2-28004]
Formulation, Preparation, and Storage
Preparation Method
Tissue specimens are homogenized in modified RIPA buffer to obtain the soluble proteins, and centrifuged to clarify. The pellet was further extracted with a second buffer to obtain the less soluble protein fraction. The lysate solution may appear turbid at cold temperatures due to insolubility of buffer components. The solution should clear upon warming to room temperature.
Concentration
1 mg/ml
Shipping
The product is shipped with dry ice or equivalent. Upon receipt, store it immediately at the temperature recommended below.
Storage
Store at -20C short term. Aliquot and store at -70C long term. Avoid freeze-thaw cycles.
Background: Breast
Additional Breast Products
Product Documents for Human Breast Tissue Lysate (Adult Tumor)
Product Specific Notices for Human Breast Tissue Lysate (Adult Tumor)
The vial is provided with a 10% overfill. Maximum recovery can be obtained by centrifuging the vial briefly to collect any solution on the cap and tube sides.
This product is for research use only and is not approved for use in humans or in clinical diagnosis. Lysates are guaranteed for 6 months from date of receipt.
Loading...
Loading...
Loading...